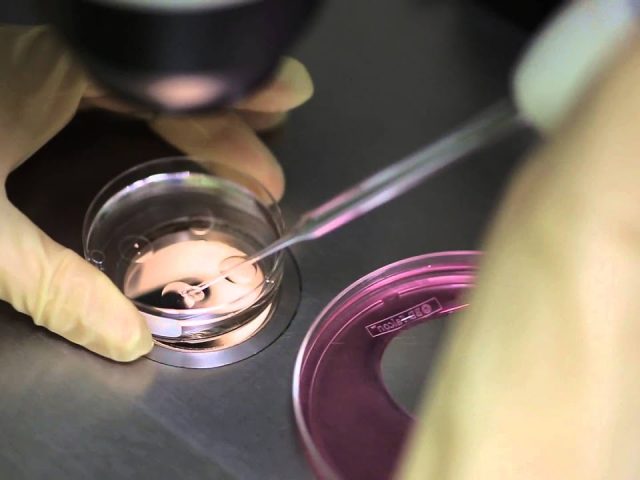

Safe and effective treatment processes at NOVAART with our professional staff.
With over 10 years of experience, we bring you one step closer to your dream.
With our personalized approach, we tailor every step to your specific needs.
We plan the most suitable IVF process for you and your partner with a free preliminary examination.
Our Services
Treatment Process
Stage 1: Assessment and Preparation
The goal at this initial and critical stage is to identify all factors preventing pregnancy. Both partners undergo detailed testing (ovarian reserve and uterine structure for women, sperm and genetic analysis for men). Once the underlying cause of infertility is found, the necessary preparatory steps and surgical procedures (e.g., hysteroscopy for uterine problems or micro-TESE to obtain sperm) are performed to increase the chances of pregnancy. Based on all this data, the most suitable IVF treatment protocol for the couple is determined and the implementation phase begins.
Stage 2: Treatment and Laboratory Process
At this stage, the core procedures of the treatment—egg development and embryo creation—are performed. The woman is treated with hormone medications for 10–12 days to develop multiple eggs, and this process is closely monitored via ultrasound. The mature eggs are retrieved under anesthesia and fertilized with sperm (ICSI) in the laboratory to create embryos. The embryos are observed for 3 to 5 days, and the highest quality one is selected; assisted implantation is also performed during this process if necessary to support implantation.
Stage 3: Transfer and Follow-up Process
In this final stage of treatment, the highest quality embryo or embryos selected in the laboratory are transferred to the mother’s uterus through a painless procedure. Following this transfer, supportive medications such as progesterone (Luteal Phase Support) are initiated to prepare the uterine lining and increase the embryo’s chances of implantation. The couple enters a critical period as they wait for the embryo to implant in the uterus. Approximately 10-12 days after the transfer, a beta-hCG test is performed on the blood to determine whether the pregnancy has been confirmed. If the test result is positive, regular pregnancy monitoring begins.
OUR TEAM
OUR LATEST ARTICLES
NOVAART in Numbers
OUR SATISFIED PATIENT
Our greatest motivation is our ever-growing number of happy couples. We look forward to welcoming you to the place where dreams come true.
OUR TEAM
From our IVF specialist to our embryologist; from our dietitian to our nurses, we at the NOVAART Family share in your happiness.
YEARS IN IVF SECTOR
For over 10 years, we have been the place where dreams come true, thanks to our thousands of happy couples, our expert staff, and our unwavering motivation.
Our Working Hours
Our Contact Information